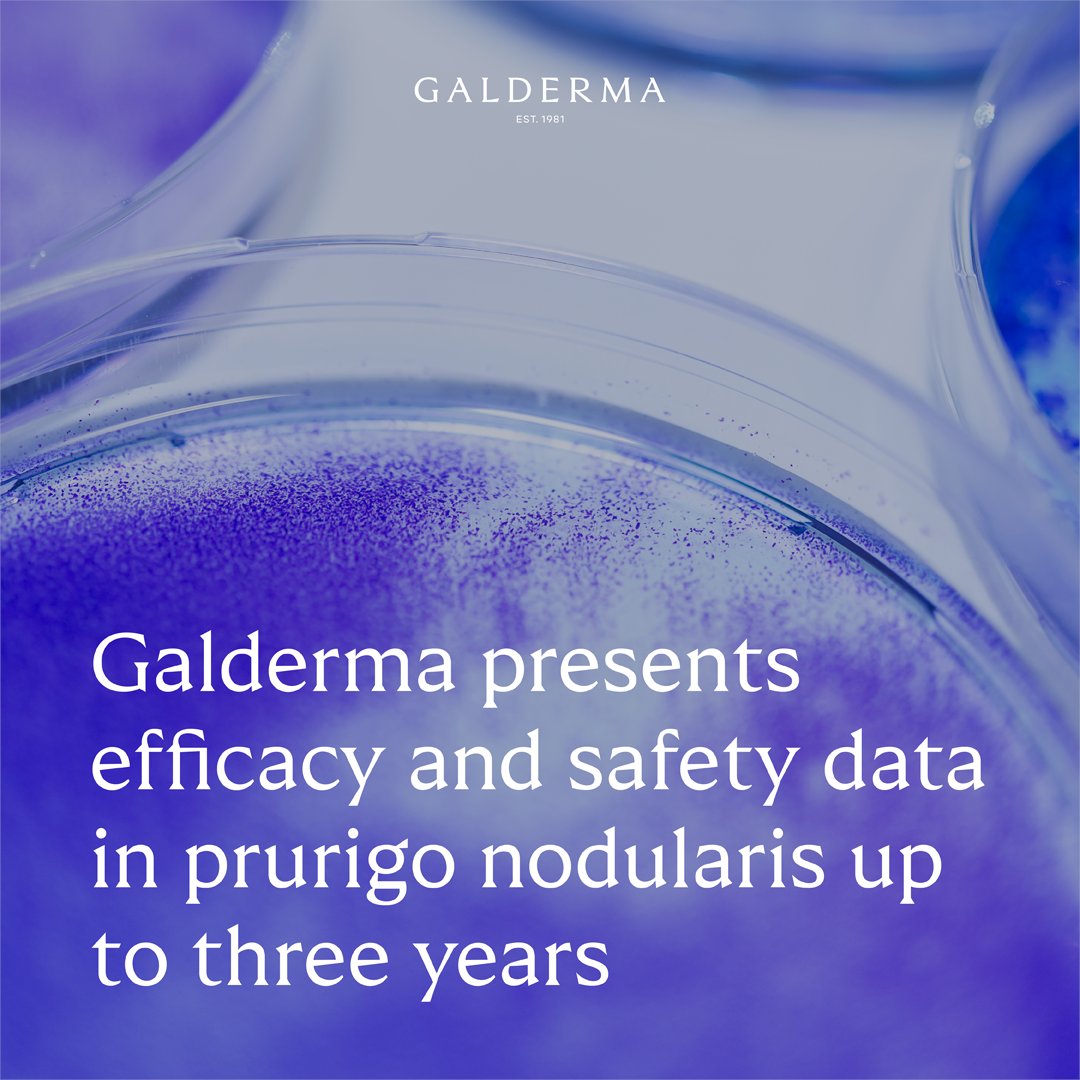
Galderma tweet media

Sabitlenmiş Tweet

FY 2025 results: Galderma achieved record net sales of 5.207 billion USD, surpassing annual sales of 5 billion USD for the first time, growing 17.7% year-on-year at constant currency. Read more: galderma.com/news/galderma-…
#AdvancingDermatology #FYResults2025 $GALD
English